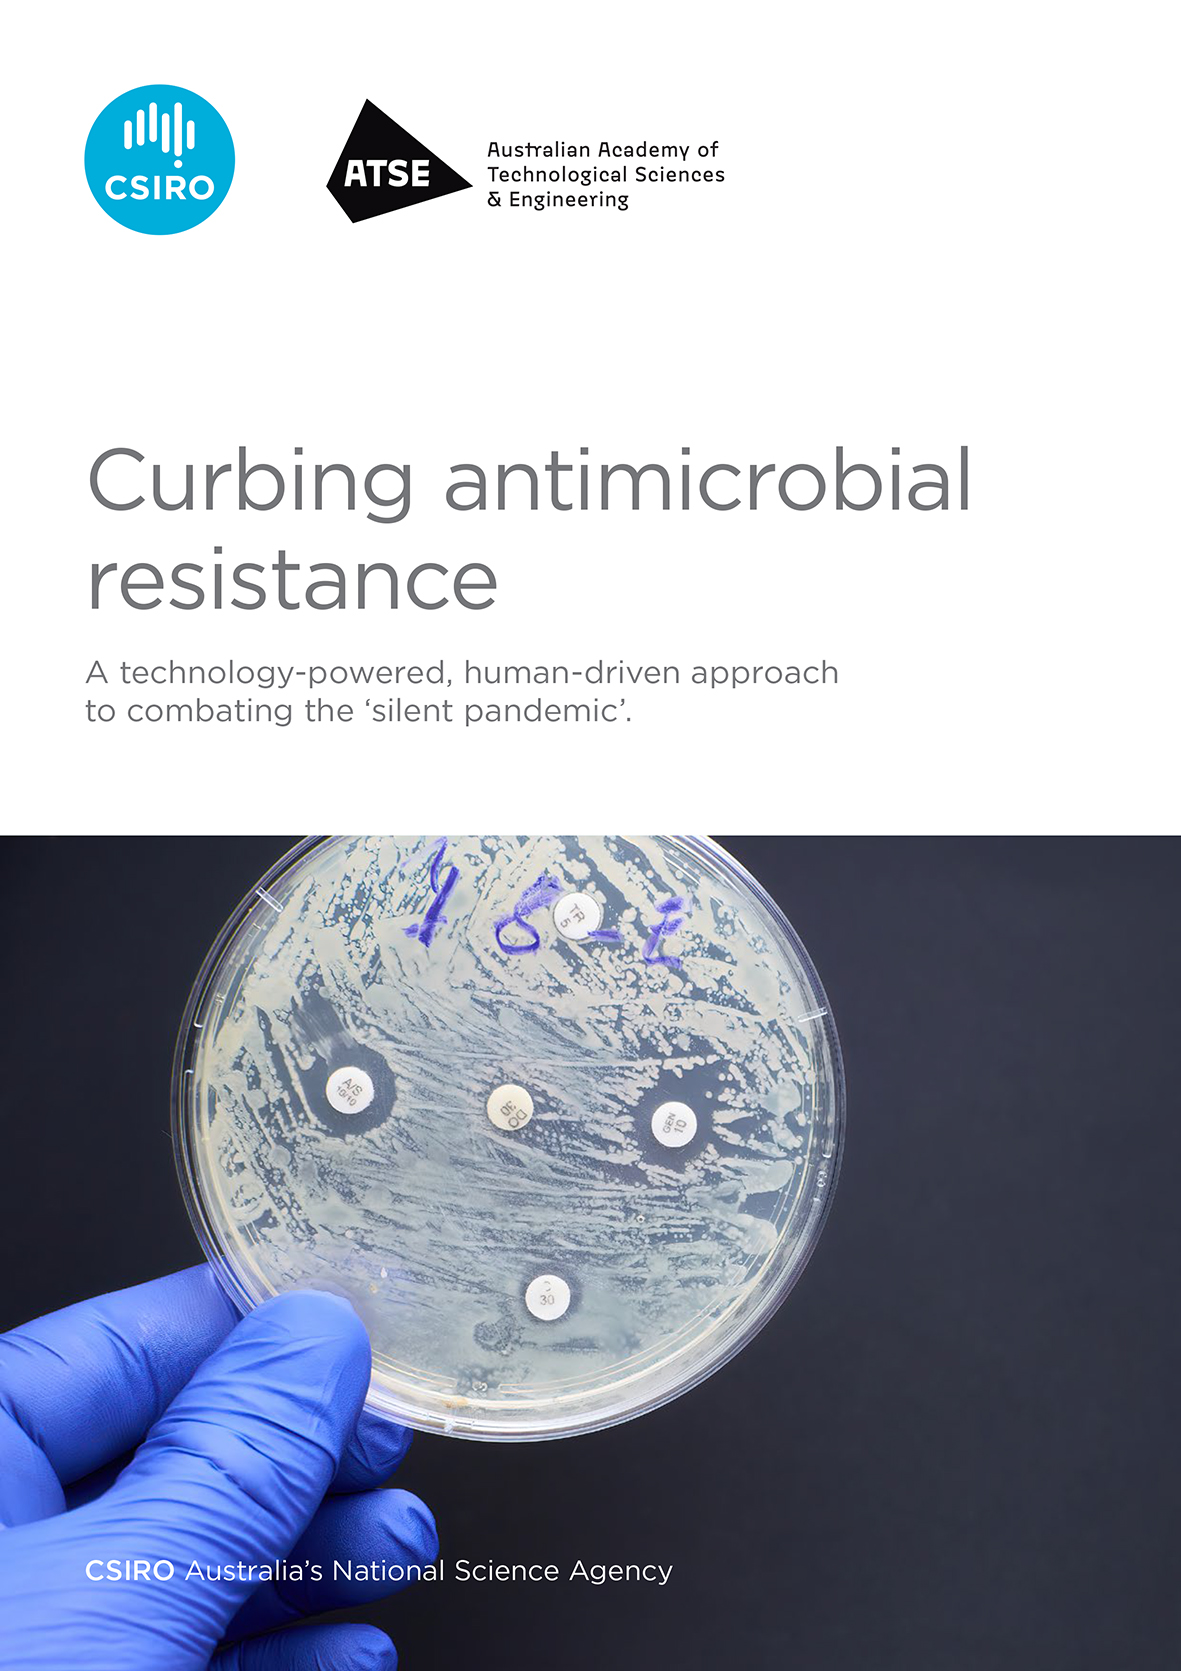

A technology-powered, human-driven approach to combating the ‘silent pandemic’.
Australia has the potential to be a strong global contributor in the development of technologies to combat antimicrobial resistance (AMR).
Australia has the potential to be a strong global contributor in the development of technologies to combat antimicrobial resistance (AMR).
The challenge is ensuring creative and practical solutions make it through the commercialisation process to the places they are needed.
The report, Curbing antimicrobial resistance: A technology-powered, human-driven approach to combating the ‘silent pandemic’, outlines the challenges Australia and the world need to overcome to avoid being thrust back into a pre-antimicrobial age where simple infections are deadly and some surgeries are too risky to perform.
The report calls for greater national coordination and a focus on streamlining commercialisation processes for new antimicrobial resistance solutions and technologies.
Download the report
The report was developed by the Australian Academy of Technological Sciences and Engineering (ATSE) and initiated by CSIRO.
A looming global health crisis
Australia is seeing a growing 'silent pandemic’ of AMR - when bacteria and other microbes become resistant to the drugs designed to kill them, such as antibiotics, usually from misuse or overuse.
It is considered a looming global health crisis, recently designated one of the top 10 public health threats facing humanity by the World Health Organization (WHO).
AMR is the process whereby microorganisms, such as bacteria, become resistant to the effects of antibiotics and other drugs used to treat infections.
Loss of effective antimicrobial treatments would be catastrophic for human and animal health.
AMR can lead to the emergence of “superbugs” that are resistant to all available treatments and can cause life-threatening infections. Without preventative action it is estimated that, by 2050, AMR could cause more than 10 million deaths per year and cost the global economy US$100 trillion.
Focusing on new and emerging technology-based solutions
Rather than focus on the discovery of new antibiotics, this report has honed in on new and emerging technology-based solutions that could prevent the evolution and spread of resistance. These technologies would help Australia and the rest of the world maintain and extend the effectiveness of antibiotics for longer. We focused on preventative technologies that can make an impact on human, animal, and environmental health, now and into the future.
The report drew on the expertise of more than 100 multidisciplinary experts across government, academia and industry and looked at a range of potentially impactful technologies such as:
- integrated surveillance and sensing solutions;
- point-of-care diagnostics;
- vaccination technologies; and
- preventative designs for use in high-risk settings.
Stakeholders were also asked to assess Australia’s readiness to adopt, adapt, or further develop the prioritised potential solutions identified.
These findings highlight where Australia is ready to realise the benefits of these solutions, and the areas where more work is needed.

A technology-powered, human-driven approach to combating the ‘silent pandemic’.
Australia has the potential to be a strong global contributor in the development of technologies to combat antimicrobial resistance (AMR).
The challenge is ensuring creative and practical solutions make it through the commercialisation process to the places they are needed.
The report, Curbing antimicrobial resistance: A technology-powered, human-driven approach to combating the ‘silent pandemic’, outlines the challenges Australia and the world need to overcome to avoid being thrust back into a pre-antimicrobial age where simple infections are deadly and some surgeries are too risky to perform.
The report calls for greater national coordination and a focus on streamlining commercialisation processes for new antimicrobial resistance solutions and technologies.
Download the report
- Curbing Antimicrobial Resistance PDF (4 MB)
- Curbing Antimicrobial Resistance - accessible text only TXT (245 KB)
The report was developed by the Australian Academy of Technological Sciences and Engineering (ATSE) and initiated by CSIRO.
A looming global health crisis
Australia is seeing a growing 'silent pandemic’ of AMR - when bacteria and other microbes become resistant to the drugs designed to kill them, such as antibiotics, usually from misuse or overuse.
It is considered a looming global health crisis, recently designated one of the top 10 public health threats facing humanity by the World Health Organization (WHO).
AMR is the process whereby microorganisms, such as bacteria, become resistant to the effects of antibiotics and other drugs used to treat infections.
Loss of effective antimicrobial treatments would be catastrophic for human and animal health.
AMR can lead to the emergence of “superbugs” that are resistant to all available treatments and can cause life-threatening infections. Without preventative action it is estimated that, by 2050, AMR could cause more than 10 million deaths per year and cost the global economy US$100 trillion.
Focusing on new and emerging technology-based solutions
Rather than focus on the discovery of new antibiotics, this report has honed in on new and emerging technology-based solutions that could prevent the evolution and spread of resistance. These technologies would help Australia and the rest of the world maintain and extend the effectiveness of antibiotics for longer. We focused on preventative technologies that can make an impact on human, animal, and environmental health, now and into the future.
The report drew on the expertise of more than 100 multidisciplinary experts across government, academia and industry and looked at a range of potentially impactful technologies such as:
- integrated surveillance and sensing solutions;
- point-of-care diagnostics;
- vaccination technologies; and
- preventative designs for use in high-risk settings.
Stakeholders were also asked to assess Australia’s readiness to adopt, adapt, or further develop the prioritised potential solutions identified.
These findings highlight where Australia is ready to realise the benefits of these solutions, and the areas where more work is needed.
Readiness indicator scale and readiness assessment graphic, showcasing Australia's capacity to develop and deploy the following potential technologies to curb AMR:
